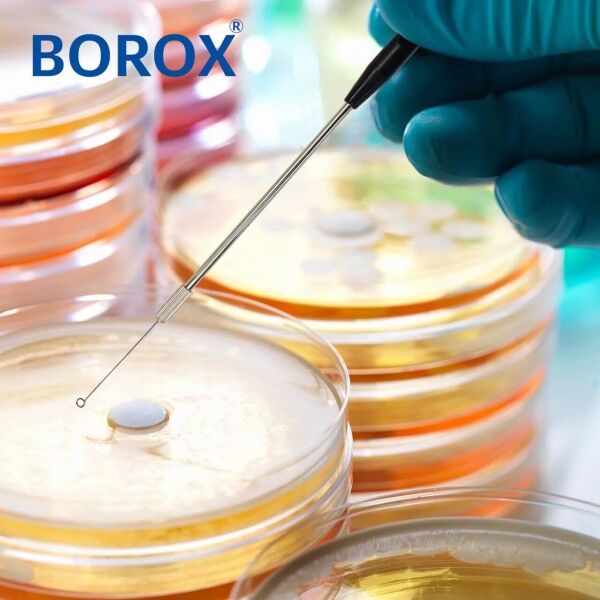
Borox Öze Ucu 4 mm - Halka Uçlu - Inoculation Loop - 10 Adet

Borox Öze Ucu 4 mm - Halka Uçlu - Inoculation Loop - 10 Adet
Ürün Kodu : S11099
Mikrobiyolojide ve bakteriyolojide kültür ekimi gibi çok amaçlı kullanımlarda ve sulu çözeltileri hazırlamada kullanırlar. Metal uçlar alev testlerinde kullanıma uygundur.
Özellikleri
-Esnek yapıları kültür ekiminin rahat ve verimli yapılmasını sağlar ve agar yüzeyinin zarar görmesini önler.
-Kullanılan hammadde antistatik yapısı gereği elektrostatik yüklenmelerden etkilenmediğinden her zaman kararlı ve tam sıvı transferi sağlarlar.
-Çift taraflı özelerde sapın diğer ucundaki sivri uç izole edilmiş kolonilerin kolay tutulma, taşınma ve sayılma işlemini sağlar. Diğer uçtaki halka ise ekim için kullanılır.
-Ürün taşıma halkaları yumuşak ve dairesel yapıda olduklarından çalışma sırasında agar yüzeyini kesmezler, delmezler ve zarar vermezler.
|
Kod |
Uzunluk(mm) |
Çap(mm) |
Malzeme |
Ambalaj adedi |
|
S11099.530 |
63 |
3 |
Nikel Kaplama |
10 adet/paket |
|
S15099.540 |
60 |
4 |
Nikel Kaplama |
10 adet/paket |
|
S11099.550 |
56 |
5 |
Nikel Kaplama |
10 adet/paket |